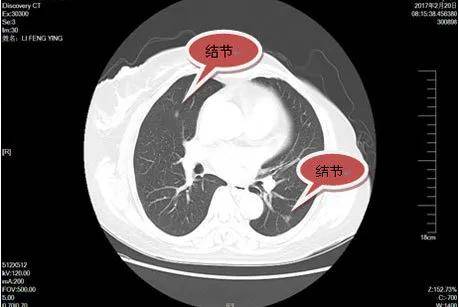

体检除了基础项目,这些项目也必不可少!
2020年08月21 14:29 来源:蜀锦传媒现在很多人意识到了健康的重要性,开始接受每年一次的体检,《中国健康和计划生育统计年鉴》的数据显示,2017年全国体检人数增长到了4.56亿人,近两年这个数字还在不断的增长。
但就算是每年体检,体检报告显示各项指标正常却仍然有可能查出重大疾病。
案例
这是身边亲戚的故事,亲戚小孩16岁,今年刚考上高中,在做入学前体检的时候被查出肠道上长了一个肿瘤。
除了每年学校会做体检之外,亲戚也会给小孩子到专门的体检医院做身体检查,为什么之前体检都很正常,但今年却查出了肿瘤呢?


很多人每年都在体检,花的钱也不少,每次体检报告上的各项指标没有任何异常,可是为什么很多癌症检查出来都已经是中晚期了?
答案很简单。
因为大多数人做的都是基本体检,这些基本项目想要筛查出癌症,几乎不可能。
大多数的人检查项目基本都是这样的:身高、体重、血压、内外科、耳鼻喉、口腔、血常规、尿常规、肝功能、肾功能、乙肝五项、血脂血糖、心电图、B超(包括肝、胆、脾、肾、甲状腺、前列腺、子宫附件)等。

这种普通的体检,只能让我们对自己的身体状况与重要的器官有一个大致的了解,对一些常见慢性病比如心血管疾病、脂肪肝等筛选比较有用,对于中晚期已经产生病变的癌症会有一个指标作用,但是如果是作为身体早期癌症的筛查几乎是不可能做到的。

“早发现、早诊断、早治疗”是目前提高癌症治愈率、降低死亡率最有效的措施。人体肿瘤从一个正常的组织细胞演变成一个直径0.5-1厘米左右的实体瘤,大概需要8-10年,这个过程中难以被B超、X光所看到。
由于个人身体状况不同,所以体检需要因人而异,才更有利于疾病的筛查。
肺部筛查
肺癌在恶心肿瘤排行一直居高不下,比第二名的胃癌总数足足多了一倍。在大多数体检套餐中X光检测肺癌分辨率低,如果胸部X光片检查诊断是肺癌,临床常常就已经到晚期了。
建议在体检使用低剂量CT进行检测,低剂量肺部CT可以判断肺部疾病有肺结核、支气管扩张、肺炎、肺部肿瘤等,肺部1-4毫米的结节都能发现。建议50岁以上的中老年人或者有肺癌家族史的人把体检中的X光片换成CT。
乳腺筛查
乳腺癌是女性最常见的恶性肿瘤之一,部分大城市报告乳腺癌占女性恶性肿瘤之首。对于乳腺的筛查建议使用乳腺彩超,这项检查对人体没有损伤,对年轻女性、致密型的乳腺比较理想。另外,还可以考虑做乳腺磁共振的检查,它可以发现多灶多中心的小病灶,也可以作为一种早期诊断的影像学检查方法。

胃部筛查
胃癌是目前发生率极高的肠胃疾病,往往临到晚期才被检查出来,我们体检时化验的红血球积压、血红蛋白、大便潜血等多个项目是无法化验出胃癌的。这些指标用于胃部疾病初步筛查还可以,如果用于胃癌筛查准确性上完不能达标。建议做胃镜筛查,这是最标准最精确的筛选方式。

肝脏筛查
肝脏实质内并没有痛觉神经,因此有些肝脏的病变患者是没有任何肝脏区域的疼痛或者不适症状,所以往往检查出肝癌时已经是中晚期,这个很容易被漏掉的区域往往让患者错过了最佳的治疗时机。
其实在做腹部B超时有一定的局限性,会大大影响到诊断的结果,因此建议40岁以后每年都做一次“甲胎蛋白+B超”联合检查,B超联合血清甲胎蛋白检测肝癌准确率达到90%以上,是临床诊断早期肝癌首选的检查方法。

宫颈筛查
和肝脏一样宫颈部位其实是没有痛感的,当宫颈癌非常严重的时候才会有一些痛觉,所以当我们反应过来的时候往往宫颈癌都是处于中晚期了。建议25岁以后女性每年做一次宫颈tct检查,宫颈tct,它是液基薄层细胞检测的简称,它是采用液基薄层细胞检测系统检测宫颈细胞并进行tbs细胞学分类诊断,是目前国际上最先进的一种宫颈癌细胞学检查技术。
虽然各个年龄段有不同的重点体验项目,但具体情况因人而异,建议在体检时充分根据自身情况,包括年龄、生活习惯、工作环境、家族史、疾病史等选择更加适合的体检项目。

注:部分图片源于网络,请作者联系我们,以奉稿酬






























